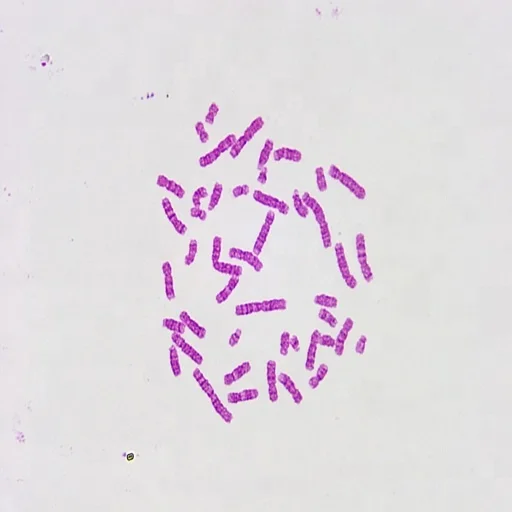
Human Histology Microscope Slides (100pcs)

Human Histology Microscope Slides (100pcs)
- Category: >>>
- Supplier: CENCE MEDIKAL VE TICARET LIMITED SIRKETI
Share on (62020794301):
Product Overview
Description
Human Histology Prepared Microscope Slides
Suitable for biology and medicine education at high schools and universities.
Ideal quality at affordable price.
1\tHuman Simple squamous Epithelium sec.
2\tHuman Simple Cuboidal Epithelium sec.
3\tHuman Simple Columnar Epithelium sec
4\tHuman Columna Pseudostratified ciliated epithelium
5\tHuman Stratified squamous Epithelium sec
6\tHuman Transitional Epithelium sec
7\tHuman Ciliated Epithelium
8\tHuman Epidermis from human mouth
9\tHuman Glandular Epithelium sec
10\tHuman Loose Connective Tissue w.m
11\tHuman Dense Connective Tissue w.m
12\tHuman Adipose Tissues sec.
13\tHuman Hyaline Cartilage sec.
14\tHuman Elastic Cartilage sec.
15\tHuman Fibro Cartilage sec.
16\tHuman Chromosome Normal Female w.m
17\tHuman Chromosome Normal Male w.m
18\tHuman Medulla oblongata sec
19\tHuman Red marrow smear
20\tHuman Smooth Muscle Teased Preparation w.m
21\tHuman Blood smear
22\tHuman Hair whole mount
23\tHuman Smooth Muscle l.s and c.s
24\tHuman Skeletal Muscle l.s and c.s
25\tHuman Cardiac Muscle sec
26\tHuman Spinal Card l.s and c.s
27\tHuman Sciatic nerve l.s.
28\tHuman Motor neuron w.m
29\tHuman Motor Nerve endings w.m.
30\tHuman Tongue l.s. show filiform papilla
31\tHuman Esophagus sec.
32\tHuman Trachea sec.
33\tHuman Stomach sec.
34\tHuman Stomach fundic portion sec.
35\tHuman Stomach Cardiac Region sec.
36\tHuman Stomach Pyloric Region sec.
37\tHuman Small Intestine c.s
38\tHuman Duodenum sec.
39\tHuman Jejunum sec.
40\tHuman Ileum c.s. show villi and goblet cells
41\tHuman Appendix sec.
42\tHuman Large Intestine sec.
43\tHuman Colon sec.
44\tHuman Rectum sec.
45\tHuman Pancreas sec.
46\tHuman Spleen sec
47\tHuman Liver sec
48\tHuman Gall Bladder sec
49\tHuman Fat layer
50\tHuman Fibroblast
51\tHuman Nerve cells
52\tHuman Bronchiolus
53\tHuman Lung sec
54\tHuman Artery sec
55\tHuman Vein sec
56\tHuman Large artery sec
57\tHuman Large vein sec
58\tHuman Heart l.s.whole
59\tHuman Kidney l.s
60\tHuman Kidney with Blood Vessel Injected sec.
61\tHuman Ureter sec.
62\tHuman Ovary sec.
63\tHuman Placenta Human sec.
64\tHuman Sperms smear
65\tHuman Epididymis sec
66\tHuman Prostate Gland Human sec.
67\tHuman Fallopian Tube sec
68\tHuman Penis c.s
69\tHuman Cervix sec
70\tHuman Thyroid Gland sec
71\tHuman Thymus Gland sec
72\tHuman Mammary gland sec
73\tHuman Adrenal Gland sec
74\tHuman Lymph Node sec
75\tHuman Salivary gland c.s.
76\tHuman Cerebrum sec
77\tHuman Cerebellum sec
78\tHuman Pituitary gland c.s.
79\tHuman Tendon teased c.s.
80\tHuman eye entail.sec
81\tHuman Eyeball.sec
82\tHuman Skin sec show Thick Cornified Layer
83\tHuman Skin sec Through sweat Gland
84\tHuman Skin sec Through Hair Follicle
85\tHuman White fibrous tissue
86\tHuman Mucous tissue, umbilical cord
87\tHuman Decalcified bone c.s.
88\tHuman Infant developing bone section
89\tHuman Developing membrane bone
90\tHuman muscle-tendon junction l.s.
91\tHuman muscle spindle
92\tHuman Nerve bundle
93\tHuman Sympathetic ganglion
94\tHuman motor cortex section
95\tHuman sentor cortex
96\tHuman Cerebellar cortex
97\tHuman Palatine tonsil
98\tHuman thin skin from human palm section
99\tHuman fingernail.section
100\tHuman stomach-esophageal junction l.s.
Packed in plastic slides box.
The plastic box packed in carton with foam.
Immediately delivered upon the receipt of payment.
Shipment Method: By Air, TNT, DHL.
We Recommend
New Arrivals
New products from manufacturers at wholesale prices